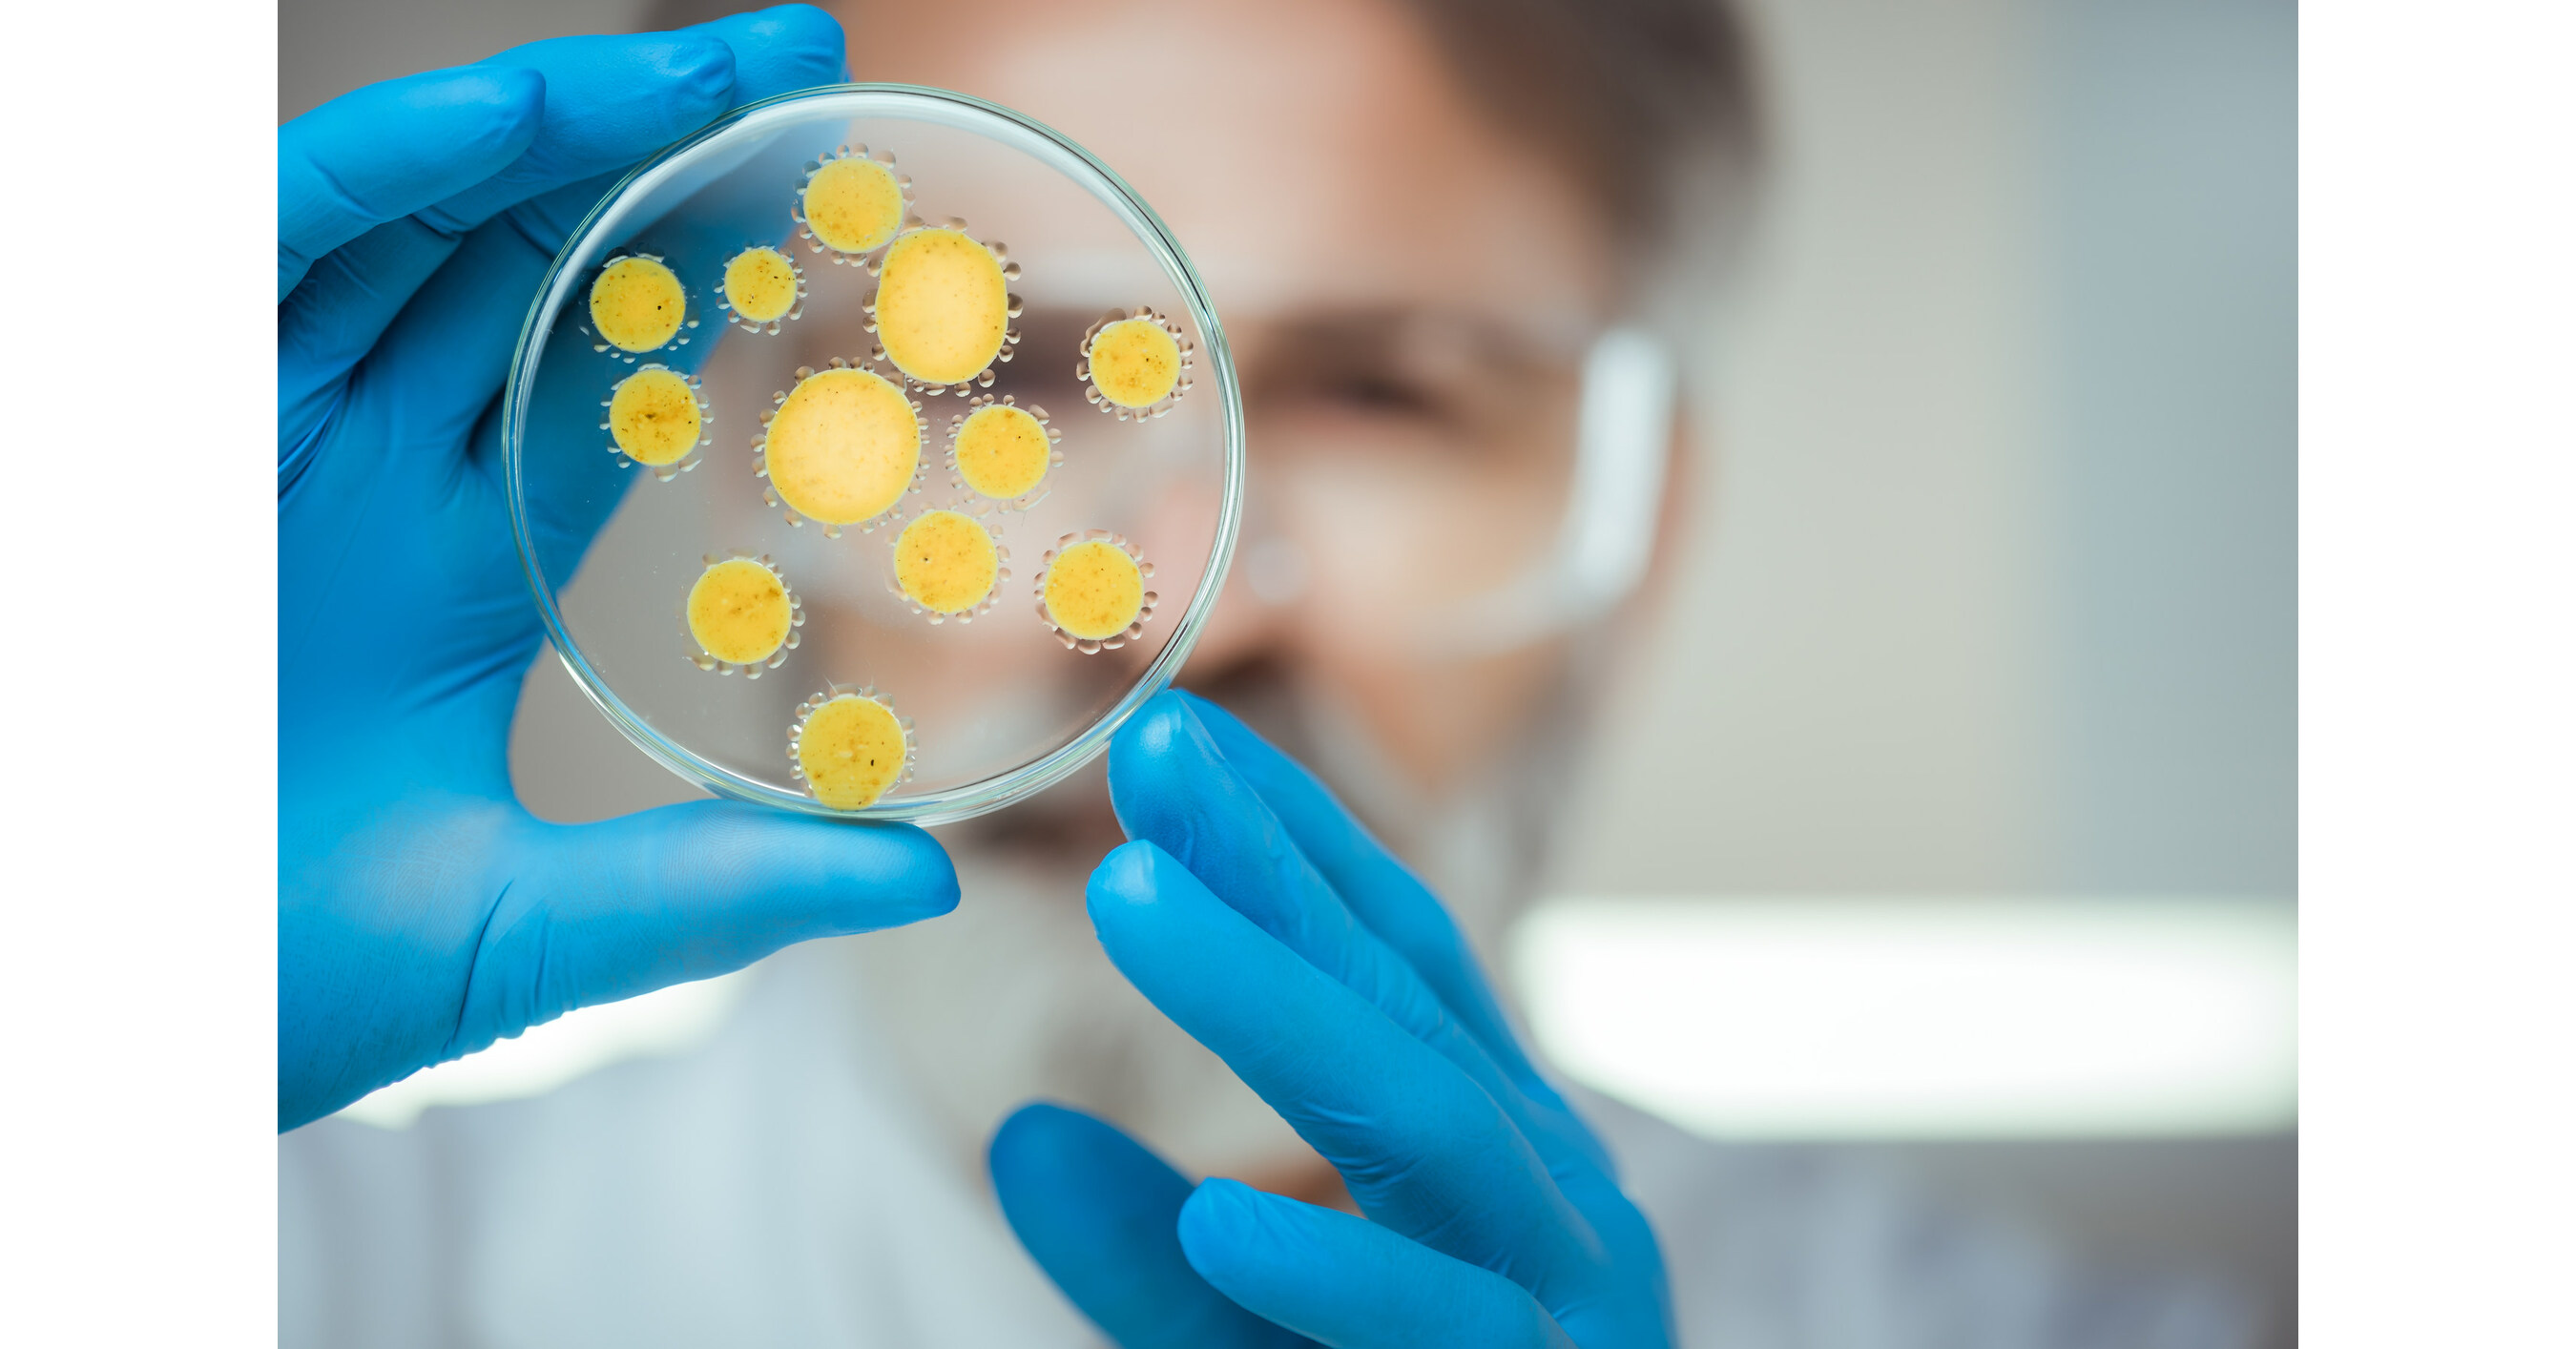

Digital Marketing Manager
Bellevue, WA (Hybrid)
Posted 4 days ago
Before you apply
Give them a reason to pay attention.
Job Summary
Original Job Description
Univar Solutions is a leading global chemical and ingredient distributor and provider of value added services to customers across a wide range of industries. With a vast supplier network, deep market and regulatory knowledge, world-class formulation and recipe development, unparalleled logistics know-how, and industry-leading digital tools, Univar Solutions is a committed ally to customers and suppliers, helping them anticipate, navigate, and leverage meaningful growth opportunities.
Unlock full insights for this role
See the hiring team, company signals, and the context that helps you decide whether this role is worth your time.
Create an account to see the full company intelligence for this role.
Traffic Signals
Headcount Trend
Marketing Team
Funding
Funding History
- Mar 2023Private Equity
AI Career Coach
Career Coach can make mistakes. Consider verifying important information.